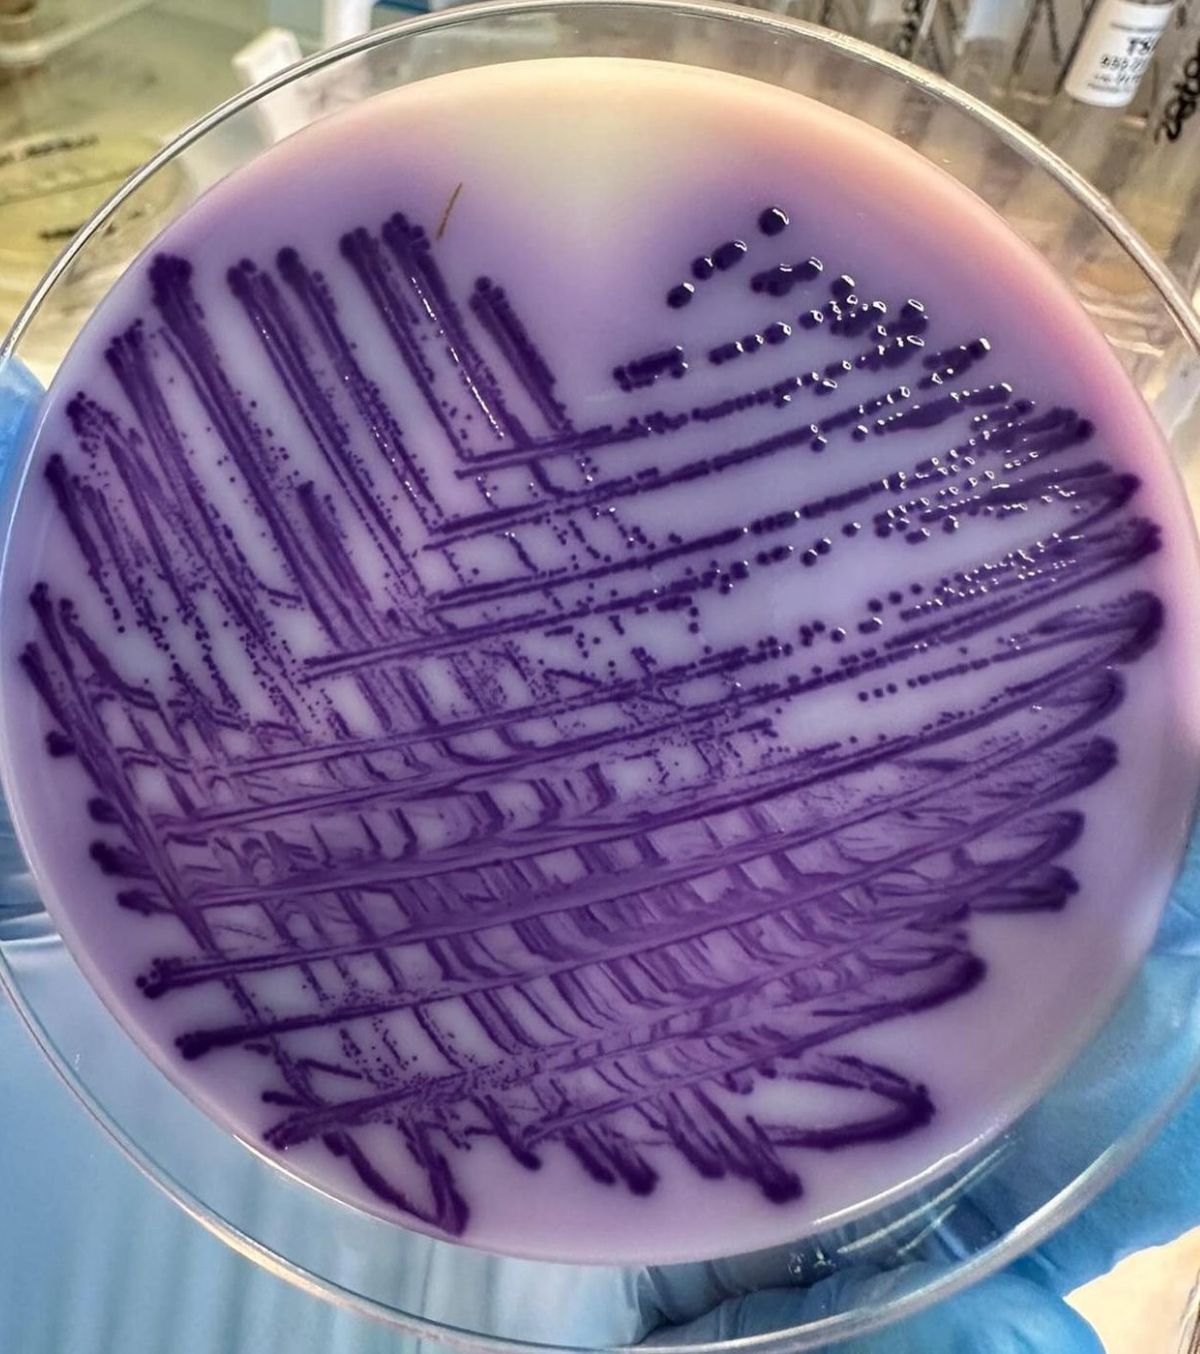

Centro di Riferimento Tipizzazione Salmonelle
Sai cos’è il CeRTiS?
Il CeRTiS è il centro di riferimento per la caratterizzazione dei microganismi responsabili di malattie alimentari per le regioni Piemonte e Liguria. CeRTiS significa Centro di Riferimento Tipizzazione Salmonelle, il centro è stato istituito nel 2011 dalla regione Piemonte per eseguire la caratterizzazione delle Salmonelle e degli altri patogeni di origine alimentare in un unico laboratorio, a cui vengono inviati i ceppi batterici isolati da uomo, animali e alimenti. Il CeRTiS è situato presso l’Istituto Zooprofilattico Sperimentale del Piemonte, Liguria e Valle d’Aosta (IZS PLVA), sede di Torino.
In Europa è attiva la sorveglianza dei casi di salmonellosi, campylobatteriosi e altre malattie dell’uomo di origine alimentare. Per le regioni Piemonte e Liguria la sorveglianza di laboratorio viene svolta dal CeRTiS, che riceve gli isolati batterici dai laboratori ospedalieri presenti sul territorio, esegue le analisi per la tipizzazione degli isolati e la determinazione delle resistenze agli antimicrobici.
Tra i numerosi microrganismi patogeni che possono contaminare gli alimenti, Salmonella e Campylobacter sono tra i più comuni e pericolosi. Campylobacter è il microrganismo più comunemente isolato in caso di infezioni alimentari in Europa. L'infezione da Campylobacter, nota come campylobatteriosi, si manifesta con sintomi gastro enterici, tra cui diarrea (spesso ematica), dolore addominale, nauseae talvolta febbre. L’infezione è comunemente associata al consumo di pollame crudo o poco cotto, acqua non trattata e latte non pastorizzato.
Salmonella è al secondo posto in Europa quale causa di infezione di origine alimentare, causa una patologia, nota come salmonellosi, che si manifesta con sintomi quali febbre, diarrea, crampi addominali e vomito. La Salmonella è spesso presente in alimenti di origine animale come carne, pollame, uova e latte non pastorizzato, ma può anche contaminare frutta e verdura.
Nel 2023 è stata effettuata presso il CeRTiS, la tipizzazione di n. 602 ceppi di Salmonella isolati in 23 laboratori ospedalieri, da coprocolture e campioni di altre matrici biologiche (sangue, urine o altri liquidi organici). La maggior parte dei ceppi clinici appartengono al sierotipo S. Typhimurium variante monofasica (36,71%), seguito da S. Stanley (10,80%), S. Enteritidis (8,97%) e da S. Typhimurium (6,15%). Per quanto riguarda Campylobacter spp., sono stati conferiti dai laboratori ospedalieri n. 488 ceppi, di cui 433 appartenenti alla specie Campylobacter jejuni, 50 alla specie Campylobacter coli, 4 alla specie Campylobacter foetus e 1 alla specie Campylobacter upsaliensis.
Tutti i ceppi di Salmonella spp. e di Campylobacter coli e C. jejuni sono stati testati per la rilevazione della resistenza agli antimicrobici con il metodo della microdiluizione in brodo. Il 63,64% degli isolati umani di Salmonella spp. è risultato sensibile a tutti gli antibiotici testati, il 43,61% resistente a 1 o 2 antibiotici, il 7,25% multiresistente (resistente a 3 o più molecole). Il 18,85% degli isolati umani di Campylobacter spp. è risultato sensibile a tutti gli antibiotici testati, il 75% resistente a 1 o 2 antibiotici, il 6,15% multiresistente.
I risultati relativi alle tipizzazioni e alle resistenze agli antimicrobici rilevate sono stati trasmessi all’Istituto Superiore di Sanità. I dati nazionali vengono trasmessi all’ECDC (European Centre for Disease Prevention and Control) e pubblicati annualmente nel report ECDC/EFSA “The European Union One Health 2022 Zoonoses Report” e nel report “The European Union Summary Report on Antimicrobial Resistance in zoonotic and indicator bacteria from humans, animals and food”.
I report 2022 sono disponibili online ai seguenti link:
Nelle foto: caratteristiche colonie di Salmonella su XLD Agar (a sinistra) e su RAPID Salmonella Agar (a destra)


